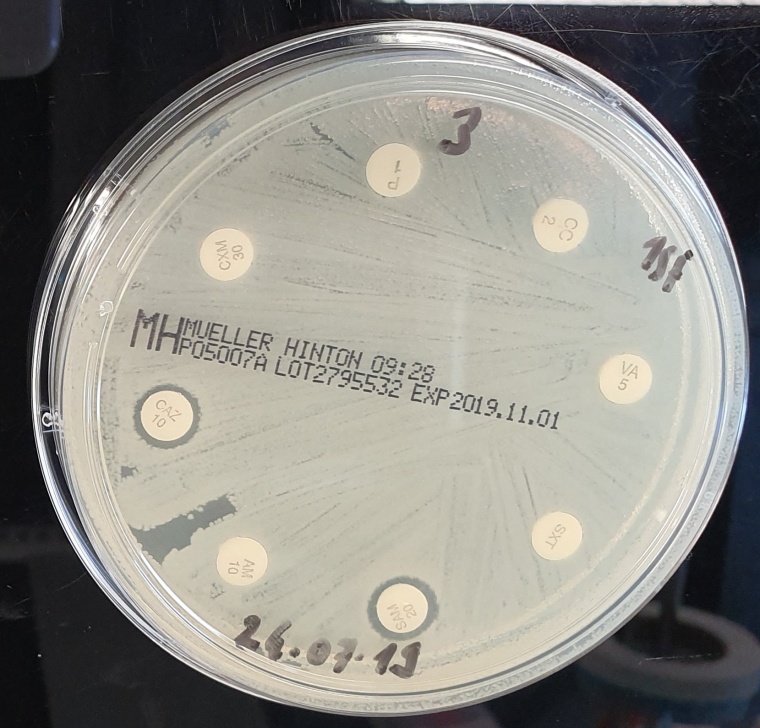
Antibiotikaresistentes Bakterium Foto: Prof. Linda Falgenhauer

Strategien im Kampf gegen spezifische Antibiotikaresistenzen
Einsatz von Carbapenemen sichern: Prof. Linda Falgenhauer vom Institut für Hygiene und Umweltmedizin der Universität Gießen ist Mitglied der internationalen AEPIC-Allianz
Multiresistente Bakterien stellen weltweit eine große Gefahr da. Sorgen bereiten Medizinern vor allem auch die zunehmenden Resistenzen gegen Antibiotika aus der Gruppe der Carbapeneme, die bislang als Reserveantibiotika bei schweren Infektionen zum Einsatz kommen, aber deren therapeutische Wirkung für die betroffenen Patienten künftig stark eingeschränkt sein könnte. Ein internationales Netzwerk, die Alliance for the Exploration of Pipelines for Inhibitors of Carbapenemases (AEPIC-Alliance), hat sich jetzt zusammengeschlossen, um interdisziplinär Strategien zur Überwindung dieser antimikrobiellen Resistenzen weiterzuentwickeln. Das Gründungskonsortium besteht aus elf Mitgliedern aus sieben Ländern: Spanien, Italien, Frankreich, Niederlande, Schweden, Kanada und Deutschland. Von deutscher Seite gehört Prof. Dr. Linda Falgenhauer vom Institut für Hygiene und Umweltmedizin der Justus-Liebig-Universität Gießen (JLU) der Allianz an.
Daten in Experimente umsetzen
Die AEPIC-Alliance wird im Rahmen des JPIAMR Network (Joint Programming Initiative on Antimicrobial Resistance) mit Hauptsitz in Schweden und vom Instituto de Salud Carlos III, Spanien gefördert. Experten aus unterschiedlichen Fachgebieten – Mikrobiologie, Infektiologie, computergestützte Biologie und Chemie, Bioinformatik, Biochemie, translationale Biologie, Biophysik, Pharmakologie, Toxikologie, Veterinärmedizin und Epidemiologie – werden sich in den kommenden zwei Jahren der Frage widmen, welcher der beste Ansatz für die systematische Anwendung computergestützter Methoden (Data Mining) bei Carbapenemase-Inhibitoren sein könnte. Außerdem geht es den Beteiligten um die Frage, wie sich die gewonnenen Daten in Experimente umsetzen lassen.
„Carbapeneme gehören zu den wirksamsten Medikamenten, die zur Behandlung von bakteriellen Infektionen zur Verfügung stehen, die gegen andere Antibiotika resistent sind“, erläutert Prof. Falgenhauer, die an der JLU die Professur für Genombasierte Surveillance und Epidemiologie multiresistenter Erreger innehat. „Allerdings werden einige Bakterien gegen diese Moleküle resistent, indem sie Enzyme produzieren, die Carbapeneme abbauen können: die Carbapenemasen. Im Fokus der Forschungsarbeiten stehen daher spezifische Hemmstoffe, die Carbapenemase-Inhibitoren. Wir müssen unbedingt verhindern, dass mit den Carbapenemen eines der wirksamsten Antibiotika unwirksam gemacht wird.“
Hochleistungscomputer für die Suche
In der AEPIC-Alliance sollen neue computergestützte Ansätze zum Tragen kommen, die mögliche Carbapenemase-Inhibitoren aufspüren. Da bei solchen Ansätzen aber auch Hochleistungscomputer sehr schnell an ihre Grenzen kommen können, werde der Erfolg stark von der Wahl der richtigen Suchparameter, Algorithmen und Datenbanken abhängen, betont die Wissenschaftlerin. Nur mit der richtigen Kombination dieser Komponenten werde es möglich sein, Moleküle für den Test in der Praxis auszuwählen. Die Aufgabe der Gießener Seite ist es, richtige Suchparameter zu definieren und neue In-vitro- und In-vivo- Teststrategien zur Untersuchung der identifizierten Carbapenemase-Inhibitoren zu entwickeln.
Falgenhauer untersucht im Rahmen des Hessischen universitären Kompetenz-Zentrums für Krankenhaushygiene (HuKKH), das vom Hessischen Ministerium für Wissenschaft und Kunst (HMWK) gefördert wird, antibiotikaresistente Bakterien, insbesondere gegen Reserveantibiotika. Es ist ihr Ziel, die Verbreitung dieser Bakterien zu verstehen und einen Beitrag zu leisten, um neue Strategien zu deren Bekämpfung zu entwickeln.













